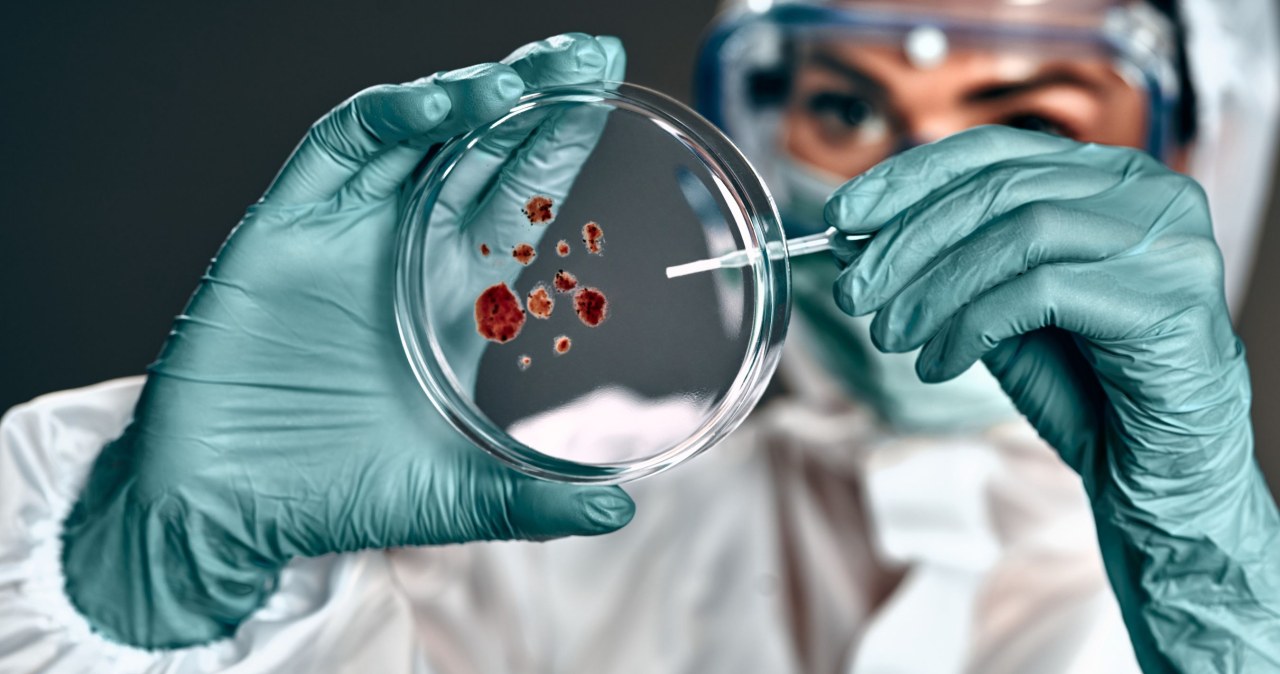
Nowa broń przeciwko grzybom. Przełom w walce z opornymi infekcjami

Nowosądecki szpital wprowadza europejską nowość w diagnostyce krwi
1 godzina temu
- Strona główna
- Medycyna lokalna
- Nowosądecki szpital wprowadza europejską nowość w diagnostyce krwi
Powiązane
Cytomammobus w drodze. Sprawdź marcowe postoje
33 minut temu
Zdrowie jest najważniejsze
1 godzina temu